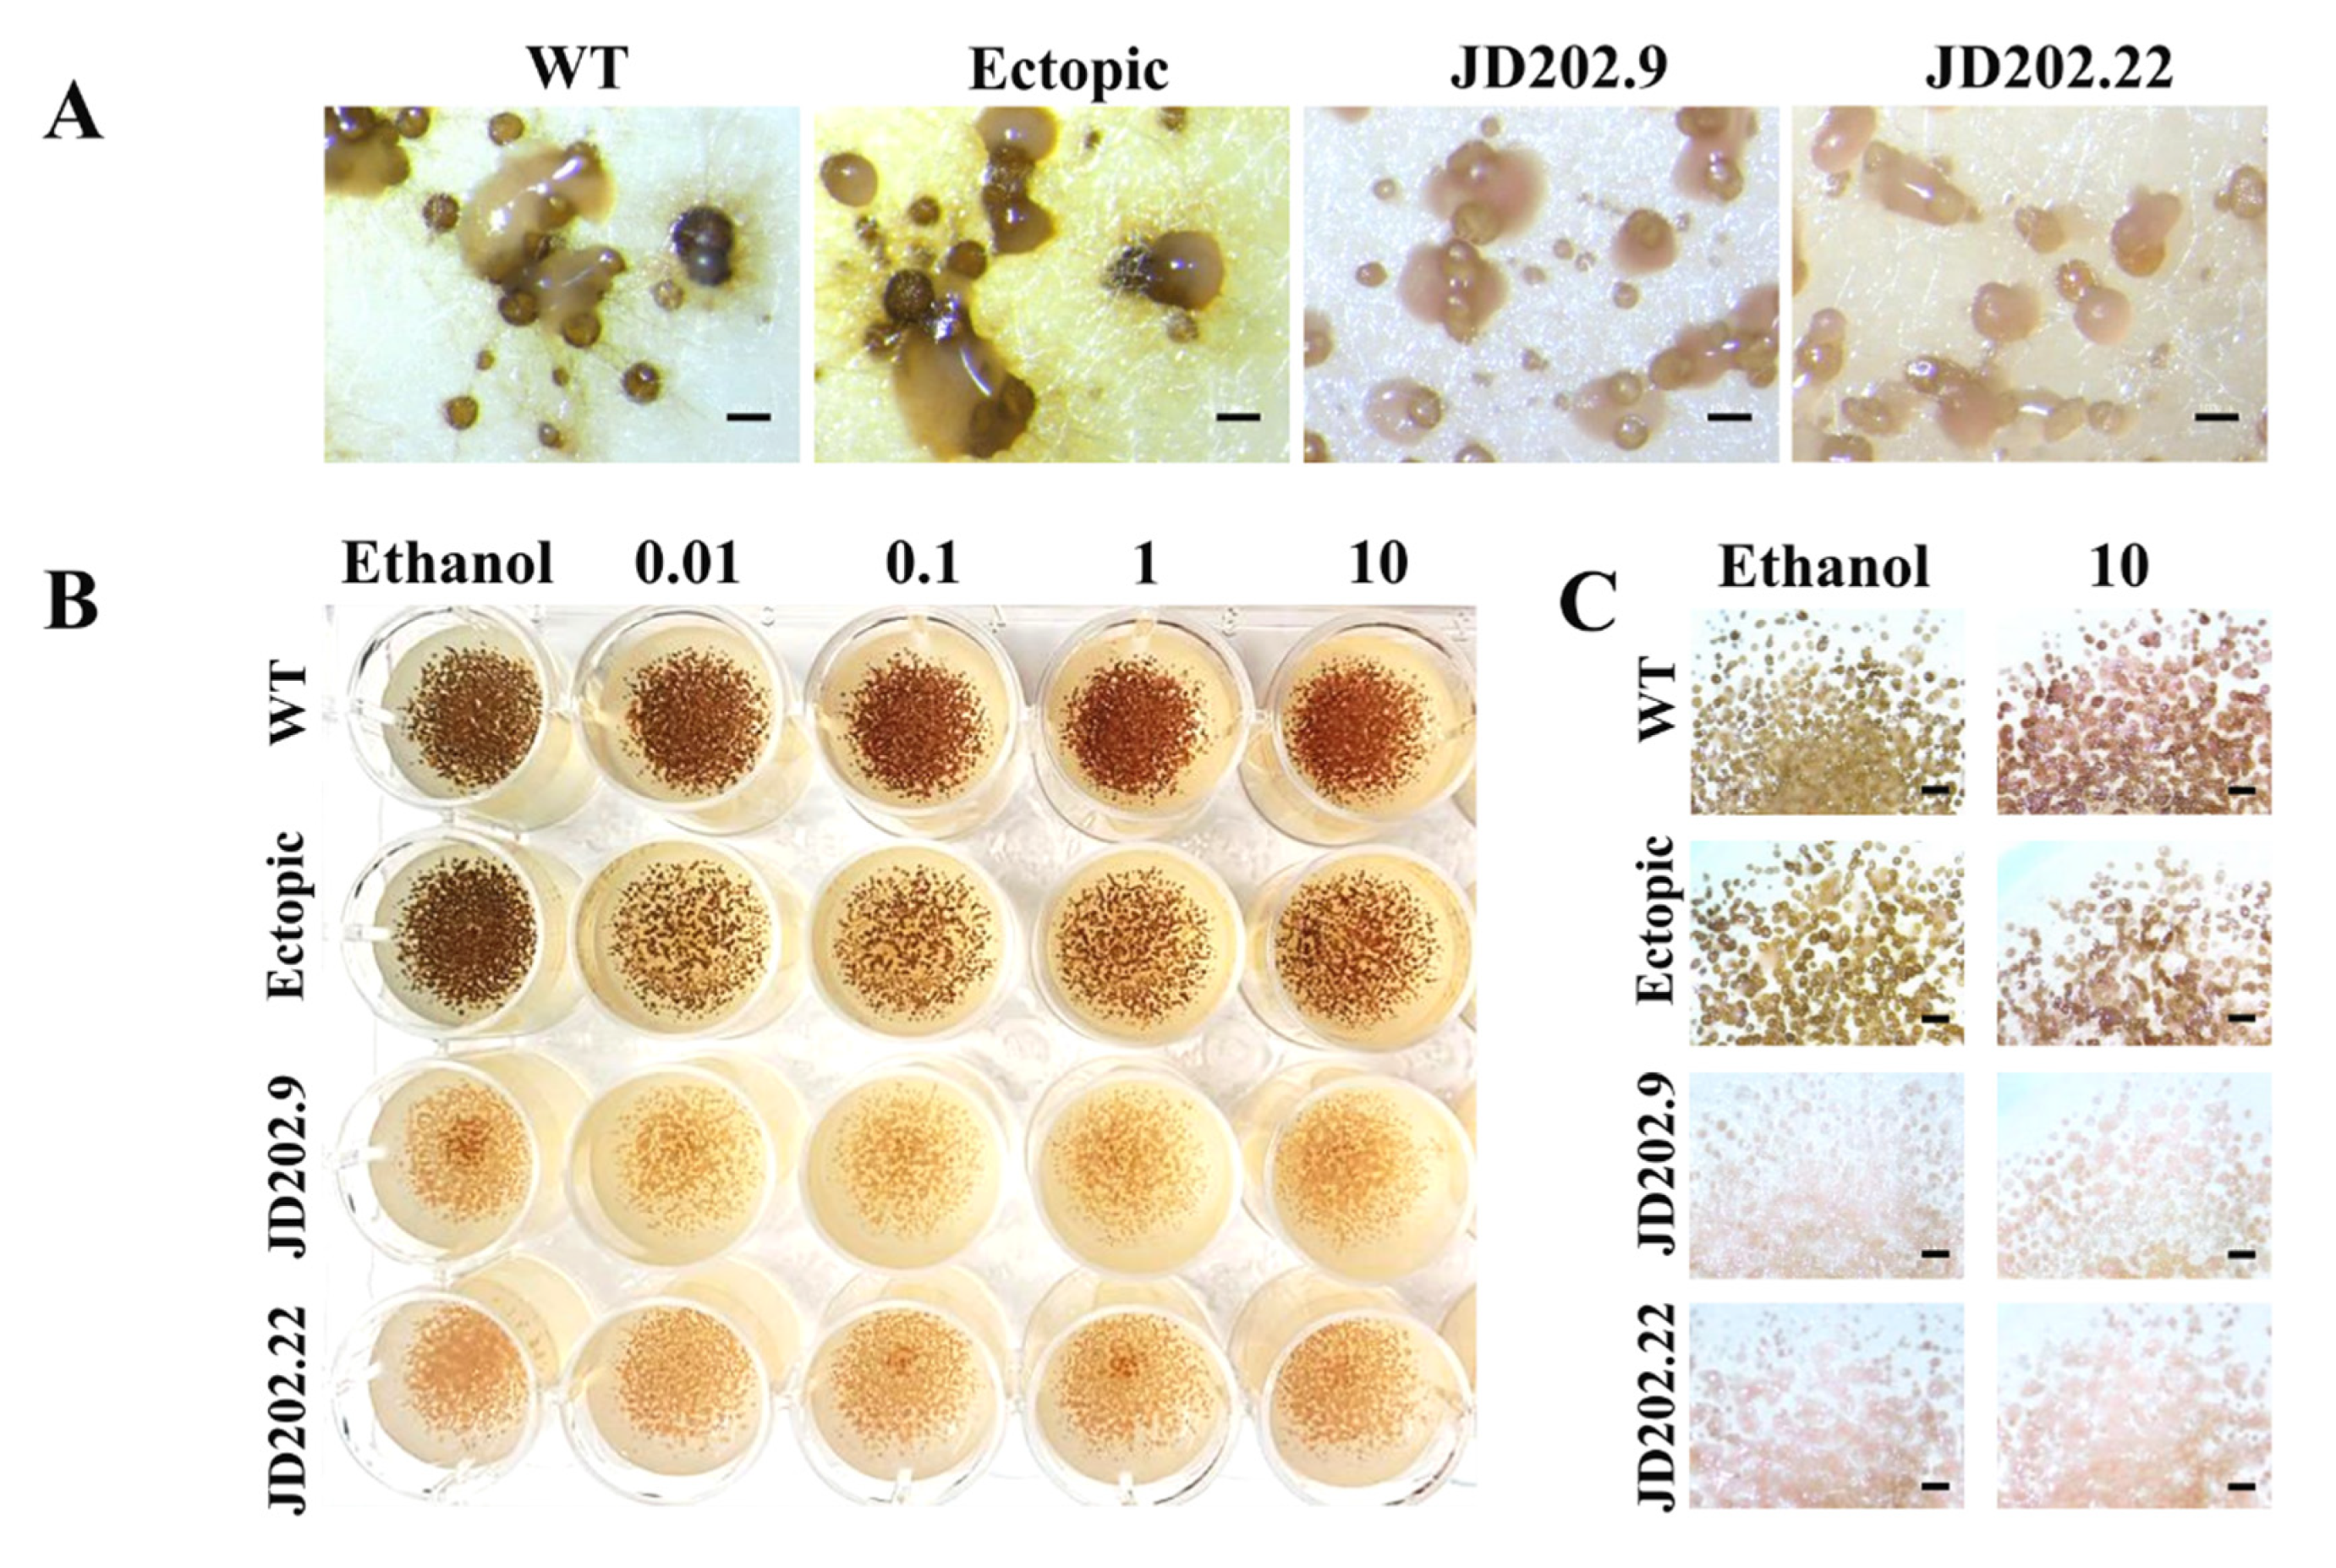
Jof 06 00314 g003 Jof 06 00314 g003

Targeted Disruption of Scytalone Dehydratase Gene Using Agrobacterium tumefaciens-Mediated Transformation Leads to Altered Melanin Production in Ascochyta lentis
Abstract
1. Introduction
2. Materials and Methods
2.1. Fungal Isolates and Plasmids
2.2. Plant Materials
2.3. Sequence and Phylogenetic Analysis
2.4. Inhibition Assay Using Tricyclazole
2.5. Construction of Disruption Plasmid for Agrobacterium Transformation
2.6. Generation of AlKewell AlSCD1 Replacement Mutant
2.7. PCR Analysis of Transformants
2.8. DNA Isolation and Nanopore Sequencing of AlKewell Isolates
2.9. Radial Colony Growth
2.10. Pathogenicity Assay
2.11. Statistical Analysis
3. Results and Discussion
3.1. Identification of Scytalone Dehydratase (AlSCD) Genes in AlKewell
3.2. Disruption of Putative AlSCD1 Gene in AlKewell
3.3. Morphological Characterization of AlSCD1 Disrupted Mutants
3.4. Pathogenicity of AlSCD1-Targeted Mutants
4. Conclusions
Supplementary Materials
Author Contributions
Funding
Acknowledgments
Conflicts of Interest
References
- Kawamura, C.; Tsujimoto, T.; Tsuge, T. Targeted Disruption of a Melanin Biosynthesis Gene Affects Conidial Development and UV Tolerance in the Japanese Pear Pathotype of Alternaria alternata. MPMI 1999, 12, 59–63. [Google Scholar] [CrossRef] [PubMed]
- Howard, R.J.; Valent, B. BREAKING AND ENTERING: Host Penetration by the Fungal Rice Blast Pathogen Magnaporthe grisea. Annu. Rev. Microbiol. 1996, 50, 491–512. [Google Scholar] [CrossRef] [PubMed]
- Kubo, Y.; Suzuki, K.; Furusawa, I.; Ishida, N.; Yamamoto, M. Relation of Appressorium Pigmentation and Penetration of Nitrocellulose Membranes by Colletotrichum lagenaria. Phytopathology 1982, 72, 498–501. [Google Scholar] [CrossRef]
- Nosanchuk, J.D.; Stark, R.E.; Casadevall, A. Fungal melanin: What do we know about structure? Front. Microbiol. 2015, 6, 1–7. [Google Scholar] [CrossRef]
- Tsai, H.F.; Fujii, I.; Watanabe, A.; Wheeler, M.H.; Chang, Y.C.; Yasuoka, Y.; Ebizuka, Y.; Kwon-Chung, K.J. Pentaketide Melanin Biosynthesis in Aspergillus fumigatus Requires Chain-length Shortening of a Heptaketide Precursor. J. Biol. Chem. 2001, 276, 29292–29298. [Google Scholar] [CrossRef]
- Watanabe, A.; Fujii, I.; Tsai, H.F.; Chang, Y.C.; Kwon-Chung, K.J.; Ebizuka, Y. Aspergillus fumigatus alb1 encodes naphthopyrone synthase when expressed in Aspergillus oryzae. FEMS Microbiol. Lett. 2000, 192, 39–44. [Google Scholar] [CrossRef]
- Schumacher, J. DHN melanin biosynthesis in the plant pathogenic fungus Botrytis cinerea is based on two developmentally regulated key enzyme (PKS)-encoding genes. Mol. Microbiol. 2016, 99, 729–748. [Google Scholar] [CrossRef]
- Saitoh, Y.; Izumitsu, K.; Morita, A.; Shimizu, K.; Tanaka, C. Cloning of Sal1, a scytalone dehydratase gene involved in melanin biosynthesis in Cochliobolus heterostrophus. Mycoscience 2012, 53, 330–334. [Google Scholar] [CrossRef]
- Tsuji, G.; Sugahara, T.; Fujii, I.; Mori, Y.; Ebizuka, Y.; Shiraishi, T.; Kubo, Y. Evidence for involvement of two naphthol reductases in the first reduction step of melanin biosynthesis pathway of Colletotrichum lagenarium. Mycol. Res. 2003, 107, 854–860. [Google Scholar] [CrossRef]
- Lundqvist, T.; Rice, J.; Hodge, C.N.; Basarab, G.S.; Pierce, J.; Lindqvist, Y. Crystal structure of scytalone dehydratase—A disease determinant of the rice pathogen, Magnaporthe grisea. Structure 1994, 2, 937–944. [Google Scholar] [CrossRef]
- Gossen, B.D.; Morrall, R. Effect of ascochyta blight on seed yield and quality of lentils. Can. J. Plant Pathol. 1983, 5, 168–173. [Google Scholar] [CrossRef]
- Murray, G.M.; Brennan, J.P. The Current and Potential Costs from Diseases of Oilseed Crops in Australia; Grains Research & Development Corporation: Barton, Australia, 2012. [Google Scholar]
- Rodda, M.S.; Davidson, J.; Javid, M.; Sudheesh, S.; Blake, S.; Forster, J.W.; Kaur, S. Molecular Breeding for ascochyta blight resistance in lentil: Current progress and future directions. Front. Plant Sci. 2017, 8, 1136. [Google Scholar] [CrossRef] [PubMed]
- Rubiales, D.; Fondevilla, S.; Chen, W.; Davidson, J. Editorial: Advances in ascochyta research. Front. Plant Sci. 2018, 9, 1–3. [Google Scholar] [CrossRef] [PubMed]
- Davidson, J.; Smetham, G.; Russ, M.H.; McMurray, L.; Rodda, M.; Krysinska-Kaczmarek, M.; Ford, R. Changes in aggressiveness of the Ascochyta lentis population in Southern Australia. Front. Plant Sci. 2016, 7, 1–16. [Google Scholar] [CrossRef] [PubMed]
- Akamatsu, H.O.; Chilvers, M.I.; Stewart, J.E.; Peever, T.L. Identification and function of a polyketide synthase gene responsible for 1,8-dihydroxynaphthalene-melanin pigment biosynthesis in Ascochyta rabiei. Curr. Genet. 2010, 56, 349–360. [Google Scholar] [CrossRef]
- Kim, W.; Lichtenzveig, J.; Syme, R.A.; Williams, A.H.; Peever, T.L.; Chen, W. Identification of a Polyketide Synthase Gene Responsible for Ascochitine Biosynthesis in Ascochyta fabae and Its Abrogation in Sister Taxa. mSphere 2019, 4, e00622-19. [Google Scholar] [CrossRef]
- Henares, B.M.; Debler, J.W.; Farfan-Caceres, L.M.; Grime, C.R.; Lee, R.C. Agrobacterium tumefaciens-mediated transformation and expression of GFP in Ascochyta lentis to characterize ascochyta blight disease progression in lentil. PLoS ONE 2019, 14, 1–20. [Google Scholar] [CrossRef]
- Sambasivam, P.; Taylor, P.W.J.; Ford, R. Pathogenic variation and virulence related responses of Ascochyta lentis on lentil. Eur. J. Plant Pathol. 2017, 147, 265–277. [Google Scholar] [CrossRef]
- Nguyen, T.T.; Taylor, P.W.J.; Brouwer, J.B.; Pang, E.C.K.; Ford, R. A novel source of resistance in lentil (Lens culinaris ssp. culinaris) to ascochyta blight caused by Ascochyta lentis. Australas. Plant Pathol. 2001, 30, 211–215. [Google Scholar] [CrossRef]
- Chi, M.H.; Park, S.Y.; Lee, Y.H. A Quick and Safe Method for Fungal DNA Extraction. Plant Pathol. J. 2009, 25, 108–111. [Google Scholar] [CrossRef]
- Debler, J. Quick fungal DNA extraction from colonies on plates. Protocols 2018, 16–18. [Google Scholar] [CrossRef]
- Debler, J.W.; Jones, A.; Nagar, R.; Sharp, A.; Schwessinger, B. High-molecular weight DNA extraction and small fragment removal of Ascochyta lentis. Protocols 2020, 4–10. [Google Scholar] [CrossRef]
- Xin, Z.; Chen, J. A high throughput DNA extraction method with high yield and quality. Plant Methods 2012, 8, 1–7. [Google Scholar] [CrossRef]
- Arseneau, J.R.; Steeves, R.; Laflamme, M. Modified low-salt CTAB extraction of high-quality DNA from contaminant-rich tissues. Mol. Ecol. Resour. 2017, 17, 686–693. [Google Scholar] [CrossRef]
- Koren, S.; Walenz, B.P.; Berlin, K.; Miller, J.R.; Bergman, N.H.; Phillippy, A.M. Canu: Scalable and accurate long-read assembly via adaptive k-mer weighting and repeat separation. Genome Res. 2017, 27, 722–736. [Google Scholar] [CrossRef] [PubMed]
- Belozerskaya, T.A.; Gessler, N.N.; Aver, A.A. Melanin Pigments of Fungi. In Fungal Metabolites; Mérillon, J.M., Ramawat, K.G., Eds.; Springer International Publishing: Cham, Switzerland, 2017; pp. 263–291. ISBN 9783319250014. [Google Scholar]
- Bell, A.A.; Wheeler, M.H. Biosynthesis and Functions of Fungal Melanins. Annu. Rev. Phytopathol. 1986, 24, 411–451. [Google Scholar] [CrossRef]
- Eisenman, H.; Casadevall, A. Synthesis and Assembly of fungal melanin. Appl. Microbiol. Biotechnol. 2012, 93, 931–940. [Google Scholar] [CrossRef]
- Kumar, M.; Chand, R.; Dubey, R.S.; Shah, K. Effect of tricyclazole on morphology, virulence and enzymatic alterations in pathogenic fungi Bipolaris sorokiniana for management of spot blotch disease in barley. World J. Microbiol. Biotechnol. 2015, 31, 23–35. [Google Scholar] [CrossRef]
- Wheeler, M.H.; Klich, M.A. The Effects of Tricyclazole, Pyroquilon, Phthalide, and Related Fungicides on the Production of Conidial Wall Pigments by Penicillium and Aspergillus Species. Pestic. Biochem. Physiol. 1995, 52, 125–136. [Google Scholar] [CrossRef]
- Tokousbalides, M.C.; Sisler, H.D. Site of inhibition by tricyclazole in the melanin biosynthetic pathway of Verticillium dahliae. Pestic. Biochem. Physiol. 1979, 11, 64–73. [Google Scholar] [CrossRef]
- Solomon, P.S.; Tan, K.C.; Sanchez, P.; Cooper, R.M.; Oliver, R.P. The disruption of a Gα subunit sheds new light on the pathogenicity of Stagonospora nodorum on wheat. Mol. Plant Microbe Interact. 2004, 17, 456–466. [Google Scholar] [CrossRef] [PubMed]
- Ozturk, I.K.; Chettri, P.; Dupont, P.Y.; Barnes, I.; McDougal, R.L.; Moore, G.G.; Sim, A.; Bradshaw, R.E. Evolution of polyketide synthesis in a Dothideomycete forest pathogen. Fungal Genet. Biol. 2017, 106, 42–50. [Google Scholar] [CrossRef] [PubMed]
- Chumley, F.G.; Valent, B. Genetic Analysis of Melanin-Deficient, Nonpathogenic Mutants of Magnaporthe grisea. MPMI 1990, 3, 135–143. [Google Scholar] [CrossRef]
- Tsai, H.; Washburn, R.G.; Yun, C. Aspergillus fumigatus arp1 modulates conidial pigmentation and complement deposition. Mol. Microbiol. 1997, 26, 175–183. [Google Scholar] [CrossRef] [PubMed]
- Tanabe, K.; Park, P.; Tsuge, T.; Kohmoto, K.; Nishimura, L.S. Characterization of the Mutants of Alternaria alternata Japanese Pear Pathotype Deficient in Melanin and Their Pathogenicity. Ann. Phytopathol. Soc. Jpn. 1995, 61, 27–33. [Google Scholar] [CrossRef][Green Version]
- Gibson, D.G.; Young, L.; Chuang, R.Y.; Venter, J.C.; Hutchison, C.A.; Smith, H.O. Enzymatic assembly of DNA molecules up to several hundred kilobases. Nat. Methods 2009, 6, 343–345. [Google Scholar] [CrossRef] [PubMed]
- Idnurm, A.; Bailey, A.M.; Cairns, T.C.; Elliott, C.E.; Foster, G.D.; Ianiri, G.; Jeon, J. A silver bullet in a golden age of functional genomics: The impact of Agrobacterium-mediated transformation of fungi. Fungal Biol. Biotechnol. 2017, 4, 1–28. [Google Scholar] [CrossRef]
- Wang, Q.; Coleman, J.J. Progress and Challenges: Development and Implementation of CRISPR / Cas9 Technology in Filamentous Fungi. Comput. Struct. Biotechnol. J. 2019, 17, 761–769. [Google Scholar] [CrossRef]
- Kihara, J.; Moriwaki, A.; Ueno, M.; Tokunaga, T.; Arase, S.; Honda, Y. Cloning, functional analysis and expression of a scytalone dehydratase gene (SCD1) involved in melanin biosynthesis of the phytopathogenic fungus Bipolaris oryzae. Curr. Genet. 2004, 45, 197–204. [Google Scholar] [CrossRef]
- Tanaka, C.; Kubo, Y.; Tsuda, M. Genetic analysis and characterization of Cochliobolus heterostrophus colour mutants. Mycol. Res. 1991, 95, 49–56. [Google Scholar] [CrossRef]
- Liang, Y.; Xiong, W.; Steinkellner, S.; Feng, J. Deficiency of the melanin biosynthesis genes SCD1 and THR1 affects sclerotial development and vegetative growth, but not pathogenicity, in Sclerotinia sclerotiorum. Mol. Plant Pathol. 2018, 19, 1444–1453. [Google Scholar] [CrossRef]
- Kubo, Y.; Takano, Y.; Endo, N.; Yasuda, N.; Tajima, S.; Furusawa, I. Cloning and structural analysis of the melanin biosynthesis gene SCD1 encoding scytalone dehydratase in Colletotrichum lagenarium. Appl. Environ. Microbiol. 1996, 62, 4340–4344. [Google Scholar] [CrossRef]
- Motoyama, T.; Imanishi, K.; Yamaguchi, I. cDNA Cloning, Expression, and Mutagenesis of Scytalone Dehydratase Needed for Pathogenicity of the Rice Blast Fungus, Pyricularia oryzae. Biosci. Biotechnol. Biochem. 1998, 62, 564–566. [Google Scholar] [CrossRef]
- Wang, Y.; Diguistini, S.; Bohlmann, J.; Breuil, C. Agrobacterium -meditated gene disruption using split-marker in Grosmannia clavigera, a mountain pine beetle associated pathogen. Curr. Genet. 2010, 56, 297–307. [Google Scholar] [CrossRef]
- Al-Laaeiby, A.; Kershaw, M.J.; Penn, T.J.; Thornton, C.R. Targeted disruption of melanin biosynthesis genes in the human pathogenic fungus Lomentospora prolificans and its consequences for pathogen survival. Int. J. Mol. Sci. 2016, 17, 444. [Google Scholar] [CrossRef]
- Thomma, B.P.H.J. Alternaria spp.: From general saprophyte to specific parasite. Mol. Plant Pathol. 2003, 4, 225–236. [Google Scholar] [CrossRef]
- Jayakumar, P.; Gan, Y.T.; Gossen, B.D.; Warkentin, T.D.; Banniza, S. Ascochyta blight of chickpea: Infection and host resistance mechanisms. Can. J. Plant Pathol. 2005, 27, 499–509. [Google Scholar] [CrossRef]
- Debler, J.W.; Henares, B.M.; Curtin University, Bentley, WA, USA. Unpublished observation. 2020.
- Kubo, Y.; Suzuki, K.; Furusawa, I.; Yamamoto, M. Melanin biosynthesis as a prerequisite for penetration by appressoria of Colletotrichum lagenarium: Site of inhibition by melanin-inhibiting fungicides and their action on appressoria. Pestic. Biochem. Physiol. 1985, 23, 47–55. [Google Scholar] [CrossRef]
- Howard, R.J.; Ferrari, M.A. Role of melanin in appressorium function. Exp. Mycol. 1989, 13, 403–418. [Google Scholar] [CrossRef]

| Primer Name | Sequence (5′ → 3′) | Description |
|---|---|---|
| JD421 | ATTGCGGACGTTTTTAATGTACTGGGTACCCAGAAGATGATATTGAAGGA | Forward primer hph cassette |
| JD422 | CCCAAATCAAGTTTTTTGGGGTCGGGTACCCTCTAAACAAGTGTACCTGT | Reverse primer hph cassette |
| JD423 | CGACCCCAAAAAACTTGATTTGGG | Forward primer LB |
| JD424 | CAGTACATTAAAAACGTCCGCAAT | Reverse Primer RB |
| JD448 | CATTGCGGACGTTTTTAATGTACTGGGTACAGGACGAACCATGTTTGCAT | Forward primer AlSCD1 5′ UTR |
| JD449 | AGTGCTCCTTCAATATCATCTTCTGGGTACGATGAGTTTGGTGTGTGTGA | Reverse primer AlSCD1 5′ UTR |
| JD450 | AATGCACAGGTACACTTGTTTAGAGGGTACGGTGGAGTCTGAGGATATTG | Forward primer AlSCD1 3′ UTR |
| JD451 | ACCCAAATCAAGTTTTTTGGGGTCGGGTACGTGAGCCAGCTGCGAGGGGC | Reverse primer AlSCD1 3′ UTR |
| JD452 | AGCGCAATGACAAATAGTGC | Forward primer 120 bp upstream5′ flanking region |
| JD453 | CTGTGCCTCGCGCCGCTGCA | Forward primer 120 bp downstream 3′ flanking region |
Publisher’s Note: MDPI stays neutral with regard to jurisdictional claims in published maps and institutional affiliations. |
© 2020 by the authors. Licensee MDPI, Basel, Switzerland. This article is an open access article distributed under the terms and conditions of the Creative Commons Attribution (CC BY) license (http://creativecommons.org/licenses/by/4.0/).
Share and Cite
Debler, J.W.; Henares, B.M. Targeted Disruption of Scytalone Dehydratase Gene Using Agrobacterium tumefaciens-Mediated Transformation Leads to Altered Melanin Production in Ascochyta lentis. J. Fungi 2020, 6, 314. https://doi.org/10.3390/jof6040314
Debler JW, Henares BM. Targeted Disruption of Scytalone Dehydratase Gene Using Agrobacterium tumefaciens-Mediated Transformation Leads to Altered Melanin Production in Ascochyta lentis. Journal of Fungi. 2020; 6(4):314. https://doi.org/10.3390/jof6040314
Chicago/Turabian StyleDebler, Johannes W., and Bernadette M. Henares. 2020. "Targeted Disruption of Scytalone Dehydratase Gene Using Agrobacterium tumefaciens-Mediated Transformation Leads to Altered Melanin Production in Ascochyta lentis" Journal of Fungi 6, no. 4: 314. https://doi.org/10.3390/jof6040314
APA StyleDebler, J. W., & Henares, B. M. (2020). Targeted Disruption of Scytalone Dehydratase Gene Using Agrobacterium tumefaciens-Mediated Transformation Leads to Altered Melanin Production in Ascochyta lentis. Journal of Fungi, 6(4), 314. https://doi.org/10.3390/jof6040314






